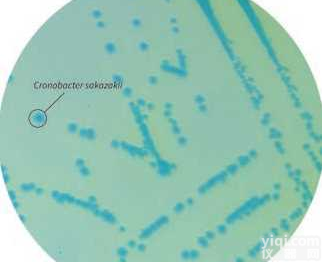
<em>阪崎肠杆菌显色培养基（改良型）</em>

阪崎肠杆菌显色培养基(改良型)
- 品牌:HiMedia
- 型号:M1641
- 供应商:北京缔一生物科技有限公司
- 供应商报价:询价
- 标签:阪崎肠杆菌显色培养基(改良型)、阪崎肠杆菌显色培养基(改良型)价格、阪崎肠杆菌显色培养基(改良型)厂家、、、北京缔一生物科技有限公司
阪崎肠杆菌显色培养基(改良型)
HiCrome Enterobacter sakazakii Agar, Modified
用途
从食品、牛奶和奶制品中选择性分离和检测阪崎氏肠杆菌。
原理
配方是根据ISO/TS 22964, 2006
显色底物检测-葡萄糖醛酸酶的存在
大肠杆菌——无色,有蓝色的ZX
产气肠杆菌——无色,有蓝色的ZX
阪崎氏肠杆菌——蓝-绿色
脱氧胆酸钠增加选择性—革兰氏阳性菌被YZ
| 货号/规格 | 名称 | 价格 |
| M1641-100G | HiCrome Enterobacter sakazakii Agar, Modified | 询价 |
| M1641-500G | HiCrome Enterobacter sakazakii Agar,Modified | 询价 |
产品引用文献
1. BS Sivamaruthi,R Madhumita,K Balamurugan,KE Rajan.Cronobacter sakazakii infection alters serotonin transporter and improved fear memory retention in the rat.Frontiers in Pharmacology,2015,6:188